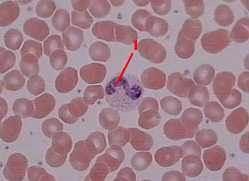
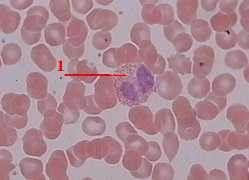

| Министерство сельского хозяйства РФ
ФГОУ ВПО Уральская Государственная Академия Ветеринарной Медицины
КОНТРОЛЬНАЯ РАБОТА
По ГИСТОЛОГИИ
Выполнила:
Студентка
Факультет:ветеринарной медицины
Троицк 2011 г.
Содержание
9) Микроскопическое и субмикроскопическое строение плазмолеммы.
11) Сперматогенез и его стадии.
29) Классификация и морфология лейкоцитов.
48) Общая схема строения органов пищеварительной трубки.
71) Как построена матка? Особенности строения ее мышечной оболочки.
Список литературы
9)
Микроскопическое и субмикроскопическое строение плазмолеммы.
Плазматическая (цитоплазматическая) мембрана или плазмалема — это обязательный компонент любой клетки. Она отграничивает клетку и обеспечивает сохранение существующих различий между клеточным содержимым и окружающей средой.
Толщина этой мембраны так мала (около 10 нм), что ее можно увидеть только в электронный микроскоп.
Животные клетки ограничены плазматической мембраной.
На ее строении, очень сходном со строением многих внутриклеточных мембран, мы остановимся несколько подробнее. Основной матрикс мембраны
состоит из липидов, главным образом фосфатидил-холина. Эти липиды состоят из головной гидрофильной группы, к которой присоединены длинные гидрофобные углеводородные цепи. В воде такие липиды спонтанно формируют двуслойную пленку толщиной 4-5 нм, в которой гидрофильные группы обращены к водной среде, а гидрофобные углеводородные цепи располагаются в два ряда, образуя безводную липидную фазу. Клеточные мембраны
представляют собой липидные бислои именно такого типа и содержат гликолипиды, холестерол и фосфолипиды.
Гидрофильная часть гликолипидов
образована олигосахаридами. Гликолипиды
всегда располагаются на наружной поверхности плазматической мембраны
, причем олигосахаридная часть молекулы ориентирована подобно волоску, погруженному в окружающую среду. Разбросанные среди фосфолипидов в почти равном с ними количестве молекулы холестерола стабилизируют мембрану. Распределение различных липидов во внутреннем и наружном слоях мембраны неодинаково, и даже в пределах одного слоя имеются участки, в которых концентрируются отдельные виды липидов. Такое неравномерное распределение, вероятно, имеет какое-то, пока еще неясное, функциональное значение.
11)
Сперматогенез и его стадии.
Сперматогенез (от греч. sperma, spermatos — семя, genesis — происхождение, возникновение) представляет собой превращение первичных половых клеток в зрелые сперматозоиды. Сперматогенез можно разделить на три основные стадии
: размножение клеток путем митоза, мейоз и спермиогенез.
Митоз первичных половых клеток
происходит на протяжении всей жизни самца, начиная с периода полового созревания.
Митотически активные клетки, находящиеся вблизи наружной стенки семенных канальцев, известны под названием сперматогоний
.
Сперматогонии А
представляют собой популяцию стволовых клеток. В ней имеется группа темных неделящихся клеток, которые, вероятно, образуют «долгосрочный резерв». Некоторые из этих клеток превращаются в митотически активные бледные клетки, а в конечном счете - в сперматогонии В,
которые делятся митотически, дифференцируются в сперматоциты 1-го порядка и вступают в мейоз.
Сперматогонии В не всегда располагаются на базальной мембране. Они отличаются от сперматогоний своими округлыми ядрами, содержащими конденсированный хроматин, располагающийся либо вблизи нуклеолеммы, либо вблизи ядрышка. В их цитоплазме содержатся свободные рибосомы, митохондрии, достаточно хорошо выраженный комплекс Гольджи, гранулярный эндоплазматический ретикулум.
Для превращения светлой сперматогонии в сперматогонию требуется четыре последовательных митотических деления, при которых генетически клетки не меняются, но происходит их морфофунюфональная перестройка. После того как в этих клетках пройдет последнее самоудвоение ДНК, они получают название прелептотенных сперматоцитов 1-го порядка,
имеющих большое ядро с хорошо видимыми обособленными хромосомами, по-прежнему содержащее их полный диплоидный набор; теперь они готовы к прохождению мейотической стадии сперматогенеза.
Сперматоциты 1-го порядка,
или первичные сперматоциты, соединены между собой межклеточными мостиками, которые остаются при митозе сперматогонии А благодаря неполному разделению клеток. Последующие поколения клеток также остаются соединенными между собой, в результате чего образуется синцитий, клетки которого составляют клон. Клетки синцития делятся синхронно, лишь единичные клетки не делятся.
Во время первого деления мейоза
(мейоз I) каждый такой сперматоцит 1-го порядка делится на две дочерние клетки. В это время на гистологическом препарате можно наблюдать характерные фигуры разделяющихся хромосом на стадиях метафазной пластинки, анафазы, обособления ядер и образования перетяжки клеток.
В результате мейоза I образуются две дочерние клетки — сперматоциты 2-го порядка,
каждый из которых содержит гаплоидный набор (23) d-хромосом (d-хромосома — хромосома после репликации ДНК, которая состоит из двух дочерних молекул ДНК). Вторичные сперматоциты расположены ближе к просвету канальца. Во время второго деления мейоза
(мейоз II) из каждого сперматоцита 2-го порядка образуются две сперматиды. Таким образом, в результате деления одной сперматогонии образуются четыре сперматиды, каждая из которых обладает гаплоидным набором хромосом
.
Сперматида
— мелкая клетка округлой формы с крупным ядром, которое впоследствии приобретает овоидную форму и располагается эксцентрично (ближе к стенке канальца).
Важная особенность сперматогенеза заключается в том, что в ходе последовательных делений цитокинез (расхождение клеток) не доходит до конца. Клетки остаются связанными между собой посредством цитоплазматических мостиков диаметром 1—2 мкм, образуя синцитий.
Поскольку молекулы и ионы легко проникают через межклеточные мостики, клетки такого клона развиваются синхронно. Такая связь нарушается только при достижении ими стадии сперматид.
Генетически сперматиды представляют собой конечный продукт мейоза. Но, прекращая деление, они подвергаются глубоким преобразованиям, превращаясь из относительно обычных на вид клеток в чрезвычайно специализированные — сперматозоиды.
Третий период сперматогенеза — превращение сперматид в сперматозоиды — носит название спермиогенез
,
или метаморфоз сперматид. В ходе сложного процесса спермиогенеза сперматиды дифференцируются в зрелые сперматозоиды. Дифференцирующие сперматиды лежат в углублениях плазматической мембраны клеток Сертоли. При спермиогенезе область ядра, обращенная к стенке семенного канальца, постепенно вытягивается и заостряется. Комплекс Гольджи формирует гранулы, которые сливаются между собой, образуя акросомальную гранулу (акробласт), контактирующую с апикальной частью ядра. Одновременно гиперплазирующиеся мешочки комплекса Гольджи окружают акросомальную гранулу, в результате чего образуется акросома, содержащая протеолитические ферменты (в основном гиалуронидазу и трипсиноподобный акрозин), которые при контакте с яйцеклеткой разрушают ее прозрачную зону. При отсутствии или недоразвитии акросомы сперматозоид теряет способность оплодотворять яйцеклетку.
Из одной центриоли начинают образовываться микротрубочки, группирующиеся сначала по три, а затем по две, к ним мигрируют митохондрии, образующие вокруг микротрубочек характерную спиральную структуру. Формируется специализированная органелла движения — жгутик.
Одновременно большинство внутриклеточных структур редуцируется. В результате примерно за 16 дней круглая сперматида со сферическим ядром превращается в чрезвычайно специализированную клетку, имеющую маленькую головку длиной 5 мкм и шириной 3 мкм, подвижный хвост длиной 50 мкм, предназначенный для единственной задачи — доставки наследственного материала отца в материнскую яйцеклетку.
В процессе спермиогенеза существенно уменьшается количество цитоплазмы формирующегося сперматозоида. Большая часть ее образует остаточное тельце, которое отделяется от клетки и фагоцитируется поддерживающим эпителиоцитом, или сустентоцитом (клеткой Сертоли). Меньшая часть цитоплазмы покрывает тонким слоем ядро, связующую, промежуточную и не полностью главную части сперматозоида. Разделение клеток одного клона происходит на последних этапах формирования сперматозоидов, которые отделяются от клеток Сертоли и попадают в просвет канальца, где находится жидкость, вырабатываемая клетками Сертоли.
29)
Классификация и морфология лейкоцитов.
Лейкоци́ты
— белые кровяные клетки; неоднородная группа различных по внешнему виду и функциям клеток крови человека или животных, выделенная по признаку отсутствия самостоятельной окраски и наличия ядра.
Классификация лейкоцитов по морфологии
· зернистые лейкоциты, или гранулоциты
— клетки имеющие крупные сегментированные ядра и обнаруживающие специфическую зернистость цитоплазмы; в зависимости от способности воспринимать красители они подразделяются на нейтрофильные, эозинофильные и базофильные;
· незернистые лейкоциты, или агранулоциты
— клетки, не имеющие специфической зернистости и содержащие простое несегментированное ядро, к ним относятся лимфоциты и моноциты.
Гранулоциты
Морфологические особенности нейтрофилов
: сегментированное ядро; в цитоплазме имеются мелкие гранулы, окрашивающиеся в слабо оксифильный (розовый) цвет, среди которых различают неспецифические азурофильные гранулы - разновидность лизосом, специфические гранулы, другие органеллы развиты слабо. Размеры в мазке 10-12 мкм.
По степени зрелости нейтрофилы подразделяются на: юные (метамиелоциты) 0-0,5 %; палочкоядерные 3-5 %; сегментоядерные (зрелые) 60-65 %.
Сегментоядерный нейтрофил.
Ядро состоит из нескольких (обычно 3-4) связанных друг с другом сегментов В цитоплазме - трудно различимая мелкая зернистость, обусловленная наличием гранул фиолетово-розового цвета.

Палочкоядерный нейтрофил.
В отличие от предыдущего случая, ядро ещё не сегментировано, а имеет форму изогнутой палочки. Зернистость в цитоплазме - по внешнему виду такая же, как в сегментоядерном нейтрофиле.
Морфологические особенности эозинофилов
: двухсегментное ядро; в цитоплазме крупная оксифильная (красная) зернистость, состоящая из двух типов гранул: специфические азурофильные - разновидность лизосом, содержащих фермент пероксидазу, неспецифические гранулы, содержащие кислую фосфатазу, другие органеллы развиты слабо.
Эозинофил
Ядро эозинофильного гранулоцита обычно состоит из двух сегментов. В цитоплазме преобладают оксифильные гранулы, окрашенные эозином в розовый цвет
Морфологические особенности базофилов
: крупное слабо сегментированное ядро; в цитоплазме содержатся крупные гранулы, окрашивающиеся основными красителями, метахроматично, за счет содержания в них гликозоаминогликанов - гепарина, а также гистамина, серотонина и других биологически активных веществ; другие органеллы развиты слабо.
Базофил.
Цитоплазма содержит большое количество круглых базофильных гранул фиолетово-вишнёвого цвета, сквозь них просматривается ядро. У базофилов ядро обычно имеет слабодольчатую структуру, но разглядеть последнюю не всегда удаётся.

Агранулоциты
Морфологические особенности лимфоцитов
По размерам: малые 4,5-6 мкм; средние 7-10 мкм; большие - больше 10 мкм.
В периферической крови около 90 % составляют малые лимфоциты и 10-12 % средние лимфоциты. Большие лимфоциты в нормальных условиях в периферической крови не встречаются. Электронно-микроскопически малые лимфоциты подразделяются на светлые (70-75 %) и темные (12-13 %).
Морфология малых лимфоцитов:
· относительно крупное круглое ядро, состоящее в основном из гетерохроматина (особенно в мелких темных лимфоцитах); узкий ободок базофильной цитоплазмы, в которой содержатся свободные рибосомы и слабо выраженные органеллы - эндоплазматическая сеть, единичные митохондрии и лизосомы.
Морфология средних лимфоцитов:
· более крупное и более рыхлое ядро, состоящее из эухроматина в центре и гетерохроматинапо периферии; в цитоплазме более развиты гранулярная и гладкая эндоплазматическая сеть, пластинчатый комплекс, больше митохондрий.
· 
Морфологические особенности м
оноцитов
Моноциты - значительно крупнее: в мазке, распластываясь по стеклу, имеют в диаметре 18-20 мкм.Ядро - бобовидное или подковообразное, светлое. Цитоплазма составляет заметную часть клетки, менее базофильна и возле ядра может содержать несколько гранул.
В этом поле зрения - два моноцита, они более, чем вдвое, крупнее окружающих эритроцитов. Ядро - бобовидное, а цитоплазма имеет вид светлого широкого ободка.
48) Общая схема строения органов пищеварительной трубки.
Органы пищеварени я делят на четыре отдела: головную, переднюю, среднюю и заднюю кишки. Головная кишка подразделяется на ротовую полость и глотку. Передняя кишка включает пищевод и желудок. Среднюю, или тонкую, кишку делят на двенадцатиперстную, тощую и подвздошную кишки. К этому отделу пищеварительного тракта относятся печень и поджелудочная железа. Заднюю, или толстую, кишку разделяют на слепую, ободочную и прямую кишки с анусом.
Ротовая полость образована нижней и верхней челюстями, рез-цовыми, нёбными костями, подъязычной костью. К органам ротовой полости относятся губы, щеки, зубы, десны, язык, твердое и мягкое нёбо, слюнные железы и миндалины. У разных животных в связи с характером выполняемой функции строение их различно.
Губы. Различают верхнюю и нижнюю губы. Они представляют собой кожно-мышечно-слизистые складки и служат для захватывания и осязания корма и приема воды.
Губы крупного рогатого скота толстые, короткие, малоподвижные. На верхней губе образуется носо-губное зеркало. У свиньи верхняя губа переходит в хоботок. У мелких жвачных и лошади губы длинные, подвижные.
Щеки образуют боковую стенку ротовой полости. Состоят из кожи, мышц и слизистой оболочки.
Зубы - очень твердые органы, служащие для захватывания, удержания и измельчения корма. Они помещаются в зубных луночках верхней и нижней челюстей, а также резцовой кости.
На зубе различают корень, шейку и коронку . Коронка зуба состоит из эмали, дентина и пульпы, а корень - из цемента, дентина и пульпы. Исключение составляют зубы лошади, у которых цемент простирается на коронку, а эмаль - на корень.
Различают резцы, клыки, коренные зубы, которые подразделяются на премоляры и моляры. У всех животных зубы бывают двух поколений: молочные и постоянные. Число зубов различно - у жвачных животных 32 зуба, отсутствуют верхние резцы, у свиньи - 42, у лошадей - у самцов 40, у самок 36, так как отсутствуют клыки.
С возрастом животного меняется форма жевательной поверхности зуба, а также форма зубной аркады. Поперечное сечение зуба меняется от поперечно-овального на округлое, затем на треугольное и, наконец, на продольно-овальное. Это изменение формы зуба дает возможность определить возраст животного.
Десны - слизистая оболочка, окружающая шейку зуба с губной, щечной и язычной поверхностей.
Язык - мышечный орган, расположенный на дне ротовой полости. При помощи языка происходит осязание и обследование корма на вкус, прием воды и корма, пережевывание, проглатывание пищи. Различают корень, тело и верхушку языка . Верхняя его поверхность называется спинкой. Слизистая оболочка языка покрыта сосочками: нитевидными, конусовидными, выполняющими механическую функцию; грибовидными, желобоватыми и листовидными, которые снабжены вкусовыми луковицами.
У животных разных видов язык устроен неодинаково. На спинке языка жвачных животных имеется подушка, отсутствуют листовидные сосочки, но желобоватых сосочков имеется 8-17 пар. У свиньи язык длинный, узкий, желобоватых сосочков только одна пара. У лошади язык длинный, отсутствуют конусовидные сосочки, желобоватых одна пара.
Твердое нёбо образует свод ротовой полости. В основе твердого нёба находится костное нёбо. На слизистой оболочке твердого нёба располагаются нёбные валики, а по середине проходит нёбный шов. Число нёбных валиков у домашних животных различно.
Мягкое нёбо, или нёбная занавеска, является продолжение твердого нёба. Во время акта глотания мягкое нёбо закрывав вход в носовую полость. Оно состоит из мышц и слизистой оболочки.
Слюнные железы открывают свои протоки в ротовую полость. Имеется три пары слюнных желез: околоушные, подчелюстные и подъязычные.
Околоушные железы лежат под кожей у основания ушной раковины. Выводные протоки этих желез открываются в защечное пространство. Подчелюстные слюнные железы находятся в межчелюстном пространстве ниже околоушной железы. Проток железы открывается на дне ротовой полости в подъязычной бородавке. Подъязычные слюнные железы лежат в подъязычной складке слизистой оболочки дна ротовой полости, сбоку от языка. У рогатого скота и свиней эта железа состоит из двух частей - коротко- и длиннопротоковой. У лошади имеется только короткопротоковая железа. Выводной проток у длиннопротоковой железы открывается вместе с протоком подчелюстной железы, у короткопротоко-вой - по ходу железы.
Миндалины в ротовой полости выполняют защитную функцию. Различают язычную и нёбные миндалины.
Глотка - это воронкообразный орган, стенка которого состоит из трех слоев: слизистой, мышечной оболочек и рыхлой соединительной ткани (адвентиции). Глотка соединяет ротовую полость с пищеводом и носовую полость с гортанью. Двойная функция глотки отражена в строении ее слизистой оболочки. Мышечный слой глотки образован тремя парами мышц-констрикторов. При помощи отверстий слуховых труб глотка сообщается со средним ухом. В слизистой оболочке глотки располагаются миндалины.
Пищевод представляет собой трубку, соединяющую глотку с желудком. Различают шейную, грудную и короткую брюшную части пищевода. Стенка его состоит из трех слоев - слизистого, мышечного и серозного в грудном и брюшном отделах и из рыхлой соединительной ткани (адвентиции) в шейном.
Желудок - это расширение пищеварительной трубки в брюшной полости. Различают однокамерные и многокамерные желудки. По строению слизистой оболочки - желудки кишечного, или железистого, типа (у собаки) и пищеводно-кишечного, или смешанного, типа (у лошади и свиньи). В желудках первого типа вся слизистая оболочка выстлана однослойным цилиндрическим эпителием и содержит железы. В желудках смешанного типа часть слизистой оболочки лишена желез и покрыта плоским многослойным эпителием.
Место входа в желудок называется кардиальной частью, а место выхода двенадцатиперстной кишки - пилорической частью, средняя часть желудка - это его дно. Различают большую и малую кривизны, а также переднюю - диафрагмальную и заднюю - висцеральную поверхности. Стенка желудка состоит из трех оболочек: слизистой, мышечной, серозной, которая образует сальники малый и большой.
Тонкая кишка простирается от пилоруса желудка до слепой кишки и делится на двенадцатиперстную, тощую и подвздошную кишку.
Стенка кишечника состоит из слизистой, мышечной и серозной оболочек. Слизистая оболочка тонкой кишки имеет огромное число кишечных ворсинок, благодаря которым увеличивается всасывающая поверхность кишечника. По всему кишечнику на слизистой оболочке расположены лимфатические фолликулы и кишечные бляшки, выполняющие защитную функцию. Мышечная оболочка представлена гладкой мышечной тканью и состоит из продольного поверхностного и кольцевого глубокого слоев. Попеременное сокращение этих слоев вызывает перистальтику кишечника. Серозная оболочка, покрывающая кишечник, переходит в брыжейку, на которой он подвешен к позвоночному столбу.
Двенадцатиперстная кишка выходит из желудка и подвешена на короткой брыжейке, между листками которой заключена поджелудочная железа. Кишка располагается в правом подреберье, и только ее конечная часть заходит в поясничную область. В двенадцатиперстную кишку открываются протоки печени и поджелудочной железы.
Тощая кишка образует множество кишечных петель, подвешенных на длинной брыжейке.
Подвздошная кишка - это короткий участок тонкой кишки, который соединен связкой со слепой кишкой. Располагается в правом подреберье.
Печень - это самая крупная железа. На ней различают две поверхности: переднюю, прилежащую к диафрагме, и заднюю, соприкасающуюся с кишечником; два края: верхний тупой и нижний - острый. Почень разделена на доли: леву среднюю и правую. В центре задней поверхности расположены рота печени, через которые входит печеночная артерия, воротц я вена и выходит печеночный проток. Печень покрыта серозной оболочкой, которая образует связки (венечная, серповидная, треугольные), соединяющие печень с диафрагмой. Круглой связку (у плода пупочная вена) печень соединена с брюшной стенкой.
Печень состоит из печеночных долек, которые отделены друг от друга соединительной тканью. Главной функционирую частью печени являются печеночные клетки, вырабатываюц желчь. Между рядами печеночных клеток проходят кровеносцЬ1е и желчные капилляры. По желчным капиллярам желчь оттекдет в желчные протоки, которые соединяются в общий проток.
Поджелудочная железа имеет дольчатое строение и построена из альвеол и их выводных протоков. В ней различают правую, среднюю и левую доли. Проток железы открывается в двенадцатиперстную кишку либо вместе с желчным протоком (овца, лошадь, собака), либо самостоятельно.
Толстый отдел кишечника состоит из слепой, ободочной и прямой кишок и заканчивается задним проходом - анусом.
Слизистая оболочка толстой кишки лишена ворсинок. Продольные пучки мышечной оболочки собраны в тяжи - тении, благодаря чему стенка кишки образует складки и карманы.
Прямая кишка - короткий отдел толстой кишки, располагаю-щийся в тазовой полости под крестцом. Серозная оболочка покрывает только передний участок кишки, а дальше идет адвентиция.
На слизистой оболочке эпителий различный: на переднем учалке- железистый, на заднем - плоский многослойный.
Заканчивается прямая кишка анусом, приспособленным для задержания каловых масс. В анусе два сфинктера: внутренний (из гладкой мускулатуры) и наружный (из поперечнополосатой).
71)
Как построена матка? Особенности строения ее мышечной оболочки.
Матка (uterus, metria), особый отдел половых протоков у самок животных и у женщин; представляет собой расширенную часть яйцевода. Матка имеет мощную мышечную стенку и хорошо снабжается кровью. В течение полового цикла самки, в котором принято различать предтечку (проэструс), течку (эструс), послетечку (метаэструс), межтечку (диэструс) . Строение стенки матки подвергается значительным изменениям. Они, обусловленные поступлением в кровь гормонов, вырабатываемых яичником, объединяются под названием маточный цикл. Стенка матки построена из слизистой, мышечной и серозной оболочек.
Слизистая оболочка (эндометрий) покрыта однослойным цилиндрическим эпителием. В составе эпителия встречаются мерцательные и секреторные клетки, выделяющие слизистый и серозный секрет. Строение эпителиального пласта у разных сельскохозяйственных животных варьирует и зависит от периода полового цикла. Основная пластинка хорошо развита. Она состоит из рыхлой соединительной и ретикулярной тканей с незначительным количеством гладкомышечных клеток. Соединительнотканная ткань
подэпителиальной зоны характеризуется обилием клеточных элементов и ретикулиновых волокон. Глубже более интенсивное развитие приобретают коллагеновые волокна, имеющие сетевидную ориентацию. Эта зона подвергается наибольшим циклическим изменениям. Затем, направление расположения коллагеновых волоков становится радиальным. Соединительная ткань основной пластинки очень бедна эластическими волокнами и расположены они преимущественно в стенках кровеносных сосудов. Секретообразовательная функция маточных желез непостоянна. Она резко усиливается в связи с развитием желтого тела и ослабляется в период между течками.
Мышечная оболочка (миометрий) построена из гладко-мышечной ткани. Из ее клеток сформировано три слоя: внутренний - циркулярный, средний слой косо ориентированных клеток и наружный - продольный. Особенность мышечной оболочки матки - наличие в среднем слое большого количества кровеносных сосудов. Это сосудистый слой мышечной оболочки. Он четко выражен у мелких хищных животных. У коров сосудистый слой соединен с циркулярным мышечным слоем и как самостоятельный выражен только в области рогов матки. У кобыл сосудистый слой плохо заметен, так как его сосуды с мышечными элементами формируют сложные взаимоотношения. У свиней крупные кровеносные сосуды проходят главным образом в соединительной ткани основной пластинки, поэтому сосудистый слой мышечной оболочки отсутствует.
Степень развития циркулярного и продольного слоев миометрия у разных сельскохозяйственных животных также варьирует. Это обусловлено длиной маточных рогов и одно- многоплодностью животных. В связи с чем у коровы, кобылы большую толщину имеет внутренний кольцевой слой, а у свиньи, собаки, копией - оба слоя одинаковы или наружный развит интенсивнее. Может меняться длина гладкомышечной ткани. У нестельной коровы в мышечной оболочке матки она обычно равна 100 мкм, при стельности 1 мм.
Серозная оболочка (периметрии) состоит из рыхлой соединительной ткани и мезотелия. Эти ткани формируют слои, расположенные в следующей последовательности: мезотелий, базальная мембрана, слой оформленных продольно ориентированных коллагеновых волокон, слой тонких эластиновых волокон, камбиальный слой мало дифференцированных клеток, глубокий неоформленный слой. При беременности в с грозной оболочке рога матки, содержавшего плод, увеличивается толщина коллагеновых и эластиновых волокон, в камбиальном слое образуется новый оформленный коллагеновый слой, циркулярно расположенных волокон. Деструкция эластиновых волокон имеет место в поздние периоды беременности.

Список литературы
Ветеринарный справочник для владельцев собак М. В. Дорош
[ Электронный ресурс
] Режим доступа
http://assauwe.lublinec.ru/rus/stat/stat62_4.htm
Ветеринарная медицина - Ветеринария для всех [ Электронный ресурс ] Режим доступа http://www.allvet.ru/referats/65.php
Цитология, гистология, эмбриология. Александровская О.В. Радостина Т.Н., Козлов Н.А. М.: Агропромиздат, 1987. 448с.
Бергельсон Л. Д. Мембраны, молекулы, клетки. - M.: Наука, 1982.
Бельш У., Шторх Ф. Введение в цитологию и гистологию животных: Пер. с нем. - M.: Мир, 1976.
Иванов И. Ф., Ковальский П. А. Цитология, гистология, эмбриология. - M.: Колос, 1976.
|